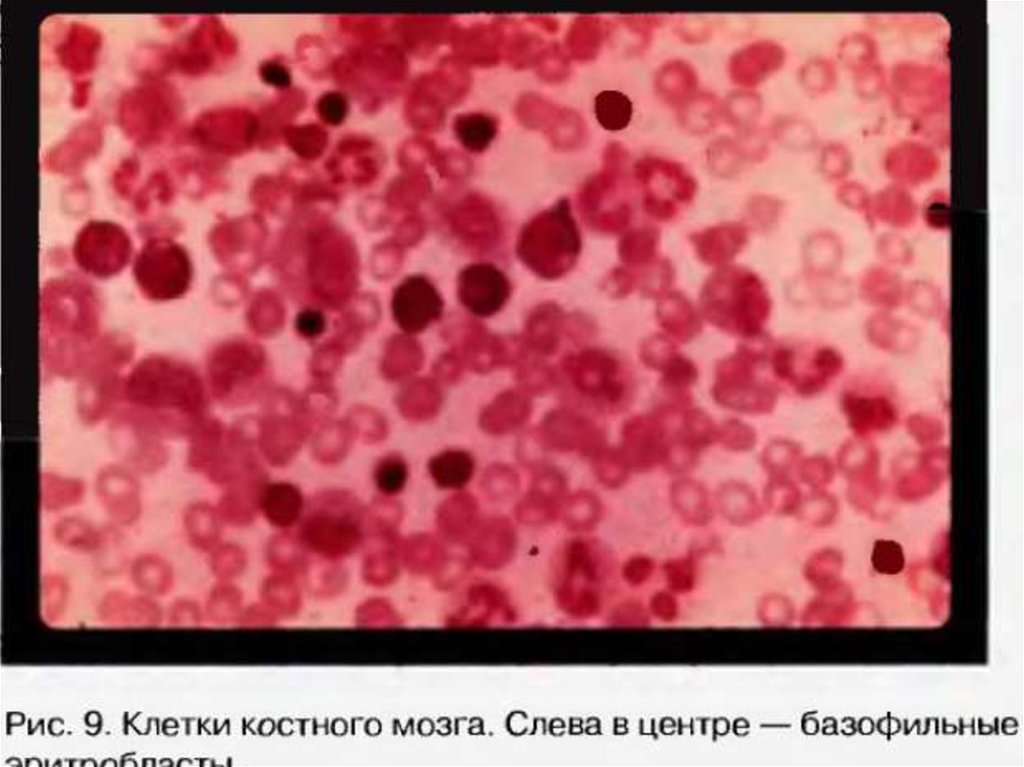

Похожие презентации:
Эритроциты
1. Вариант А (классический): к 4 мл 3% NaCl добавить 0,02 мл крови, считать по диагонали в 5 (*16)квадратах, вычислять по формуле:
Х = a*4000*200/80 , где Х – количество форменныхэлементов в 1 мкл.
а – кол-во эритроцитов, сосчитанных в 5(*16) квадратах
80 - кол-во малых квадратов (5*16=80)
–
200 – степень разведения (4:0,02)
4000 – множитель, приводящий результат к объему 1
мкл,
поскольку объем малого квадрата равен 1/400 мкл.

Медицина
Медицина








